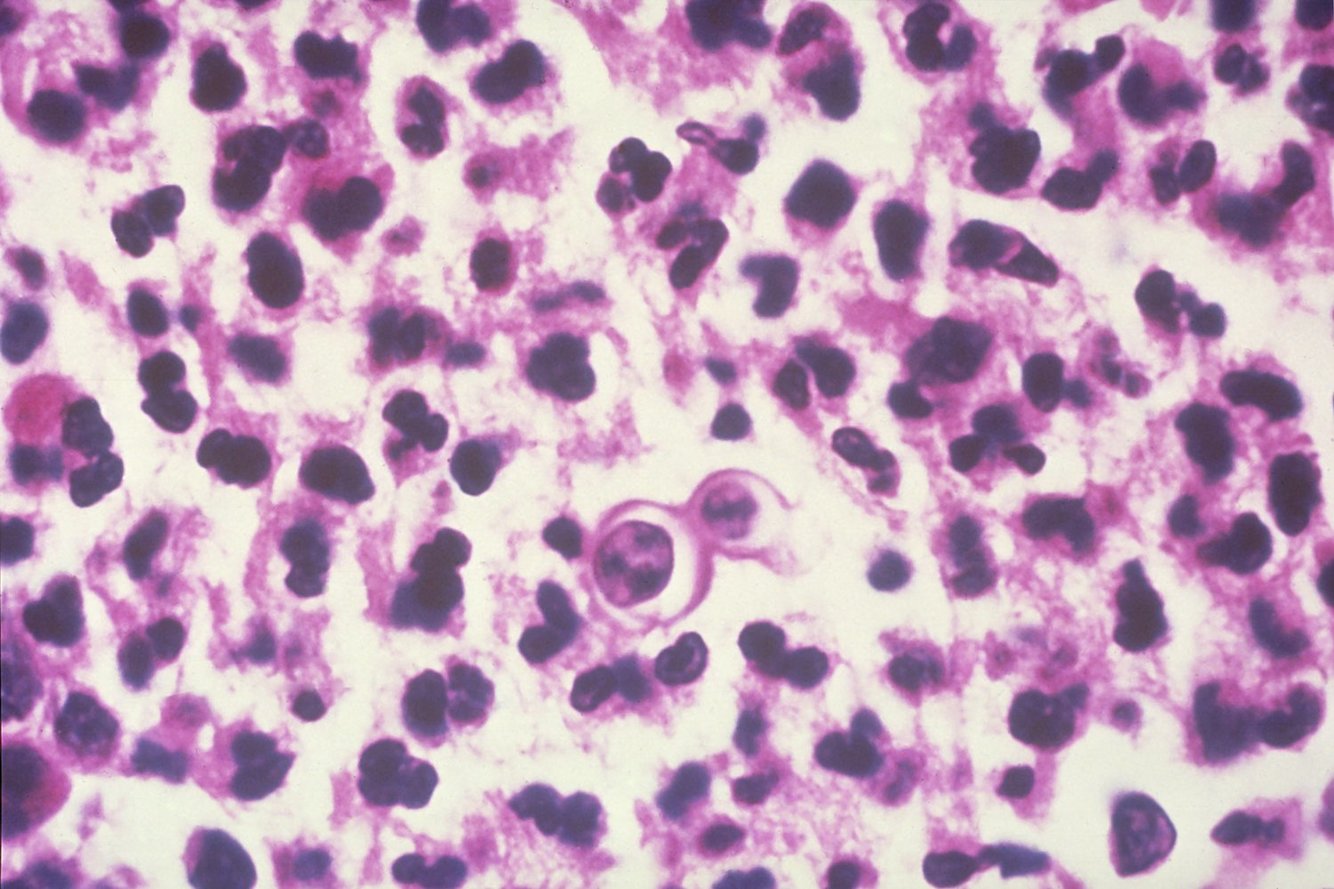

(A) Superficial dorsal vein
(B) Deep dorsal vein
(C) Dorsal artery
(D) Corpus cavernosum
(E) Corpus spongiosum

Mycobacterium tuberculosis (Ziehl-Neelse stain)

Histoplasma capsulatum (mold form)

Pneumocystis jirovecii

Mucormycosis
Blastomyces dermatitidis

Cryptococcosis

Kayser-Fleischer Ring

Influenza

Dermatitis Herpetiformis
(grouped papulovesicular eruptions with escoriations and erythematous areas surrounding the lesions)

Esophageal Squamous Cell Carcinoma

Ganglion Cyst

Angiomyolipoma associated with Tuberous Sclerosis

Iron Deficiency Anemia

Mitral Valve Prolapse

Trichomonas Vaginalis

Digital Clubbing

Ebstein Anomaly

Total Anomalous Pulmonary Venous Return

Serous Adenoma Tumor of the Ovary

Mitral Stenosis

Basal Ganglia Hemorrhage due to Chronic Hypertension

Aortic Stenosis Caused by Chronic Rheumatic Valve Disease (Fused commissures)

Aortic Dissection (Widened Mediastinum)































































































































































































